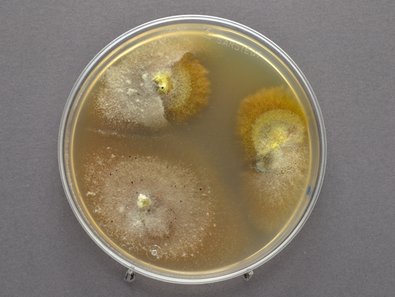

Hintergrund
Das Diplodia-Triebsterben (Dipodia sapinea) tritt seit einigen Jahren verstärkt in den Ländern im Zuständigkeitsbereich der Nordwestdeutschen Forstlichen Versuchsanstalt (NW-FVA) auf, insbesondere in Hessen und Sachsen-Anhalt (Abb. 1). Im Rahmen eines deutschlandweiten Projektes (WAHYKLAS, Waldhygienische Klimaanpassungsstrategien) wurde an der NW-FVA das Diplodia-Triebsterben der Kiefer (Pinus sylvestris) untersucht und die Endophyten in Kiefernzweigen analysiert.
Ökologische Rolle unbestimmt
Über die ökologische Rolle von Endophyten gibt es noch einiges zu forschen. Endophyten sind Organismen (meist Pilze oder Bakterien), die zumindest für einen Teil ihres Lebenszyklus in den Geweben von Pflanzen vorkommen ohne Symptome hervorzurufen. Viele Endophyten gelten als von ihrem Wirt tolerierte Parasiten. Ebenso können sie zu einem späteren Zeitpunkt als Pathogene (opportunistische oder latente Pathogene) auftreten. Vielfach sind Endophyten Primärbesiedler von absterbenden bzw. abgestorbenen Gewebebereichen ihrer Wirte. Sie liegen im Baum zunächst in einer physiologischen Ruhephase vor. Beginnen die Bäume zu altern, zersetzen sie oft das Holz und können ihre Fruchtkörper bilden.
Diplodia-Triebsterben
Der wärmeliebende Pilz Diplodia sapinea (Synonym: Sphaeropsis sapinea) tritt seit (ca.) 20 Jahren verstärkt in Kiefernbeständen des Zuständigkeitsgebietes der NW-FVA auf und ist auch bundesweit sehr verbreitet. Er löst erst Schäden aus, wenn der Pilz bei vorgeschädigten oder geschwächten Wirtspflanzen in seine parasitische Phase übergeht und das Diplodia-Triebsterben verursacht. Der Erkrankung geht in der Regel eine Schwächung der Kiefer voraus.
Im Rahmen des Projektes wurde das Diplodia-Triebsterben entlang eines Transekts von Nordost- nach Südwestdeutschland erforscht. Insgesamt wurden 190 Waldkiefern auf 105 Standorten untersucht (Abb. 3). Dazu wurden Probeäste mit Pfeil und Bogen oder von Baumkletterern geworben und zusätzlich einige Kiefern gefällt. Anschließend wurden die vorkommenden Pilzarten aus gesunden und erkrankten Probezweigen isoliert, im Labor in Reinkultur gebracht und ökologisch sowie hinsichtlich ihrer forstlichen Relevanz bewertet. Auf den Untersuchungsflächen wurde zudem das Vorkommen der Mistel, des Wurzelschwamms und sonstiger Einflussfaktoren (z.B. Nadelfraß durch Insekten) erhoben.
Viele Endophyten erstmalig isoliert
Aus den Trieben von Pinus sylvestris wurden 103 verschiedene Pilzarten isoliert, morphologisch charakterisiert und DNS-gestützt bestimmt. Davon gehören 101 Arten zu den Schlauchpilzen (Ascomyceten) und zwei zu den Ständerpilzen (Basidiomyceten). Pro Baum wurden zwischen 5 und 22 endophytische Pilzarten isoliert. Nur vier Endophytenarten kamen häufiger vor (mit einer relativen Häufigkeit von über 10 % bezogen auf alle ausgewachsenen Pilze (n ≈ 26.000).
Sydowia polyspora
Microsphaeropsis olivacea
Truncatella conorum-piceae
Diplodia sapinea
Insgesamt wurden aus Waldkiefern-Trieben 26 Endophyten identifiziert, die erstmals von Pinus silvestris isoliert wurden. Bei einem Probebaum, der monatlich auf seine Endophyten hin untersucht wurde, konnten innerhalb eines Jahres 84 verschiedene endophytische Pilzarten nachgewiesen werden. Die häufigen Pilzarten Sydowia polyspora und Microsphaeropsis olivacea zeigten klare jahreszeitliche Unterschiede in der Häufigkeit ihres Auftretens. Unter den Endophyten fanden sich viele saprophytisch lebende Arten wie z.B der Kiefern-Zystidenrindenpilz (Peniophora pini) und das Kiefernnadel-Haarbecherchen (Desmazierella acicola) sowie typische Laubholzbesiedler der Gattungen Kohlenbeeren (Hypoxylon), Kugelpilze (Daldinia) und Rindenkugelpilze (Biscogniauxia). Potenzielle Pathogene für holzige Pflanzen wurden ebenfalls isoliert, so z.B. D. sapinea, S. polyspora, T. conorum-piceae). In den untersuchten Trieben wurden keine Quarantäneschaderreger nachgewiesen.
Regionale Unterschiede
Die geografische Lage kann einen Einfluss auf die Zusammensetzung der Endophytengemeinschaft der Waldkiefer haben. Ein Beispiel hierfür ist die Südliche Kohlenbeere (= Südlicher Rindenkugelpilz, Biscogniauxia mediterranea). Die Kohlenbeere kam besonders in Südhessen und Baden-Württemberg oder an Standorten, die mit mehr Laubbäumen bzw. Eichen bestockt waren, verstärkt vor, wohingegen dieser Pilz im nördlicheren Transektgebiet seltener auftrat. Biscogniauxia mediterranea wurde als potenzielles Pathogen eingestuft, da der Pilz Schäden an Eiche in mediterranen Gebieten hervorruft. Die nah verwandte, an Rotbuchen fruchtende Art Münzenförmiger Rindenkugelpilz (Biscogniauxia nummularia) wurde in 39 % aller untersuchten Kiefernbestände nachgewiesen. Auch sie ist ein wärmeliebender Endophyt und typischer Schwächeparasit der Rotbuche. Hinsichtlich der Verkehrssicherung und Arbeitssicherheit kann B. nummularia zu ernsthaften Problemen bei Rotbuche führen, falls der Pilz in seine parasitische Phase übergeht und Holzfäule und Streifenkrebs verursacht. Dagegen spielte der Diplodia-Triebsterben-Erreger auf den untersuchten Flächen, die vom Fraß des Kiefernspinners betroffen waren, keine maßgebliche Rolle in absterbenden Beständen im Zeitraum des WAHYKLAS-Projekts.
Verstärkende Faktoren für die Erkrankung
Auslösende Faktoren für das Diplodia-Triebsterben sind nach derzeitiger Einschätzung zumeist Wasserdefizite durch Trockenheit und Hitzeperioden. Trockene, schlecht wasserversorgte Standorte begünstigen den Erkrankungsverlauf, ebenso der Befall der Kiefern mit weiteren Schaderregern. Die Untersuchungen zeigen, dass zahlreiche Faktoren an einer Diplodia-Triebsterben-Erkrankung beteiligt sein können:
prädisponierende Faktoren wie Kuppen oder Hanglagen,
devitalisierende Faktoren wie ein Befall mit Mistel oder Wurzelfäulepilzen (insbesondere Wurzelschwamm), milde Winter mit Hochwarmphasen,
schadensauslösende Faktoren wie starke Besonnung und Hitzeperioden, lang anhaltende Trockenheit oder Verletzungen der Triebe und der Rinde durch Hagelschlag.
Schlussfolgerungen
Eines der wichtigsten Ergebnisse der Untersuchungen war, dass der Diplodia-Triebsterben-Erreger (Diplodia sapinea) deutschlandweit entlang des Untersuchungs-Transekts endophytisch vorkommt. Das bedeutet zwar zunächst keine unmittelbare Gefahr für die Kiefern, zeigt aber, dass ein grundsätzliches pathogenes Potenzial durch diese Art vorhanden ist. Diplodia sapinea ist bereits in den Trieben etabliert und kann von seiner endophytischen in die parasitische (pathogene) Phase übergehen, sobald die Kiefern geschwächt sind. Die Ursachen für diesen Übergang sind sehr komplex. So zeigten Untersuchungen der NW-FVA zum Beispiel, dass auch ein starker Hagelschaden nicht automatisch zu einer Erkrankung mit dem Diplodia-Triebsterben führen muss.
Da Diplodia sapinea ein wärmeliebender Pilz ist, wird es zukünftig wahrscheinlich bedingt durch den Klimawandel zu mehr Schadensfällen kommen. Die prognostizierten trockeneren Sommer und milden Winter schwächen die Vitalität der Kiefer und machen sie anfälliger für einen Befall. Dies hat sich auch gravierend in den extrem trockenen und zu warmen Jahren 2018 und 2019 gezeigt, in denen flächige Absterbeerscheinungen in Kiefernbeständen beobachtet wurden.
Das Projekt WAHYKLAS wird unter dem Förderkennzeichen 28WC403102 vom Bundesministerium für Ernährung und Landwirtschaft (BMEL und vom Bundesministerium für Umwelt, Naturschutz, Bau und Reaktorsicherheit (BMUB) im Rahmen der Fördermaßnahme Waldklimafonds gefördert. Projektträger ist die Bundesanstalt für Landwirtschaft und Ernährung (BLE).